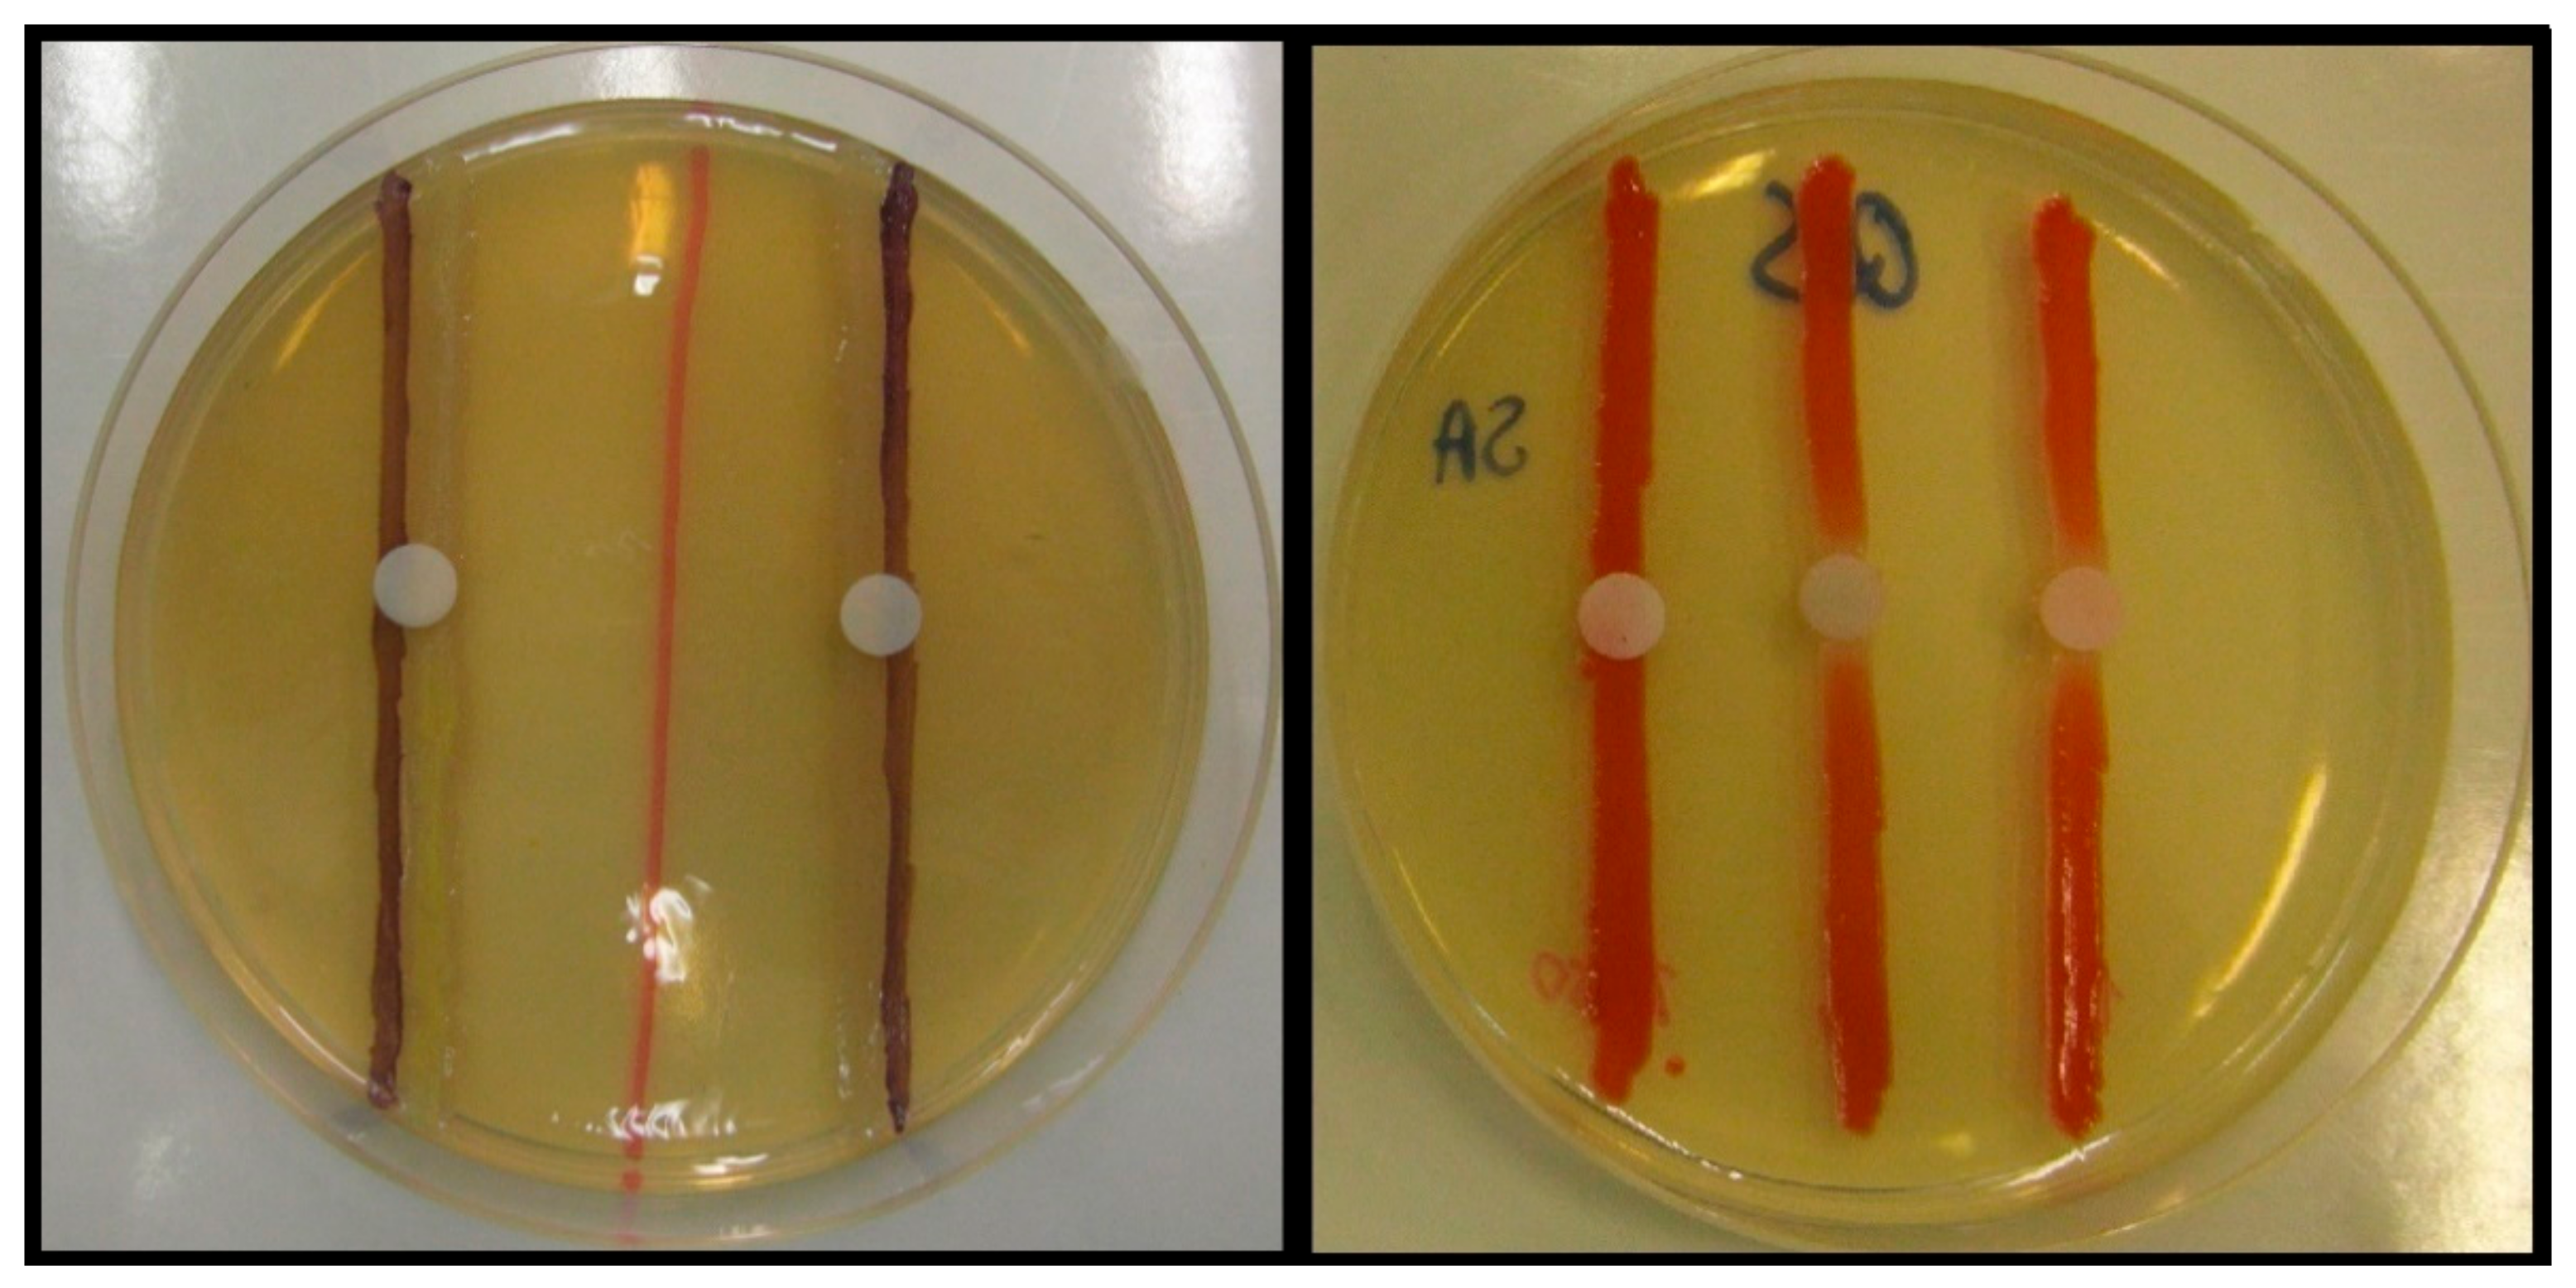
Antibiotics 08 00270 g005 Antibiotics 08 00270 g005

The Role of Drug Repurposing in the Development of Novel Antimicrobial Drugs: Non-Antibiotic Pharmacological Agents as Quorum Sensing-Inhibitors
Abstract
1. Introduction
2. Results and Discussion
2.1. Antibacterial Activity
2.2. Screening and Semi-Quantitative Assessment of QS-Inhibitory Activity
3. Materials and Methods
3.1. Chemicals
3.1.1. Pharmaceutical Compounds
3.1.2. Media Constituents and Other Reagents
3.2. Bacterial Strains
3.3. Culture Media
3.4. Antibacterial Activity
3.5. Screening for and Semi-Quantitative of QS-Inhibitory Activity Using Disk Diffusion Method
4. Conclusions
Supplementary Materials
Author Contributions
Funding
Acknowledgments
Conflicts of Interest
References
- Gaynes, R. The Discovery of Penicillin—New Insights after More Than 75 Years of Clinical Use. Emerg. Infect. Dis. 2017, 23, 849–853. [Google Scholar] [CrossRef]
- Shallcross, L.J.; Howard, S.J.; Fowler, T.; Davies, S.C. Tackling the threat of antimicrobial resistance: From policy to sustainable action. Philos Trans. R. Soc. Lond. B Biol. Sci. 2015, 370, 20140082. [Google Scholar] [CrossRef] [PubMed]
- Aslam, B.; Wang, W.; Arshad, M.I.; Khurshid, M.; Muzammil, S.; Rasool, M.H.; Nisar, M.A.; Alvi, R.F.; Aslam, M.A.; Qamar, M.U.; et al. Antibiotic resistance: A rundown of a global crisis. Infect. Drug Resist. 2018, 11, 1645–1658. [Google Scholar] [CrossRef] [PubMed]
- Nathan, C.; Cars, O. Antibiotic Resistance—Problems, Progress, and Prospects. NEJM 2014, 371, 1761–1763. [Google Scholar] [CrossRef] [PubMed]
- Cassini, A.; Högberg, L.D.; Plachouras, D.; Quattrocchi, A.; Hoxha, A.; Simonsen, G.S.; Colomb-Cotinat, M.; Kretzschmar, M.E.; Devleesschauwer, B.; Cecchini, M.; et al. Attributable deaths and disability-adjusted life-years caused by infections with antibiotic-resistant bacteria in the EU and the European Economic Area in 2015: A population-level modelling analysis. Lancet Infect. Dis. 2019, 19, 56–66. [Google Scholar] [CrossRef]
- Gajdács, M. Extra deaths due to pandrug resistant bacteria: A survey of the literature. Egészségfejlesztés 2019, 60, 31–36. [Google Scholar]
- Rice, L.B. Federal funding for the study of antimicrobial resistance in nosocomial pathogens: No ESKAPE. J. Infect. Dis. 2008, 197, 1079–1081. [Google Scholar] [CrossRef]
- Boucher, H.W.; Talbot, G.H.; Bradley, J.S.; Edwards, J.E.; Gilbert, D.; Rice, L.B.; Scheld, M.; Spellberg, B.; Bartlett, J. Bad Bugs, No Drugs: No ESKAPE! An Update from the Infectious Diseases Society of America. Clin. Infect. Dis. 2009, 48, 1–12. [Google Scholar] [CrossRef]
- Santajit, S.; Indrawattana, N. Mechanisms of Antimicrobial Resistance in ESKAPE Pathogens. Biomed. Res. Int. 2016, 2016, 2475067. [Google Scholar] [CrossRef]
- Nasim, J.; Witek, K.; Kincses, A.; Abdin, A.Y.; Żesławska, E.; Marć, M.A.; Gajdács, M.; Spengler, G.; Nitek, W.; Latacz, G.; et al. Pronounced activity of aromatic selenocyanates against multidrug resistant ESKAPE bacteria. New J. Chem. 2019, 43, 6021–6031. [Google Scholar] [CrossRef]
- World Health Organization. Antimicrobial Resistance: Global Report on Surveillance. Available online: http://apps.who.int/iris/bitstream/10665/112642/1/9789241564748_eng.pdf?ua=1 (accessed on 27 October 2019).
- CDC Antibiotic/Antimicrobial Resistance (AR/AMR). Available online: https://www.cdc.gov/drugresistance/biggest_threats.html (accessed on 27 October 2019).
- The Bacterial Challenge: Time to React. ECDC/EMEA Joint Technical Report (2009). Available online: http://ecdc.europa.eu/en/publications/Publications/0909_TER_The_Bacterial_Challenge_Time_to_React.pdf (accessed on 27 October 2019).
- Laxminarayan, R.; Duse, A.; Wattal, C.; Zaidi, A.K.M.; Wertheim, H.F.L.; Sumpradit, N.; Vlieghe, E.; Hara, G.L.; Gould, I.M.; Goossens, H.; et al. Antibiotic resistance-the need for global solutions. Lancet Infect. Dis. 2013, 13, 1057–1098. [Google Scholar] [CrossRef]
- O’Neill, J. Antimicrobial resistance: Tackling a crisis for the health and wealth of nations. Available online: https: //amr-review.org/sites/default/files/AMRReviewPaper-Tacklingacrisisforthehealthandwealthofnations_1.pdf (accessed on 27 October 2019).
- Gajdács, M.; Szabó, A. Physicians’ opinions towards antibiotic use and resistance in the southeastern region of Hungary. Orv. Hetil. 2019. accepted. [Google Scholar]
- Dyar, O.J.; Huttner, B.; Schouten, J.; Pulcini, C. What is antimicrobial stewardship? Clin. Microbiol. Infect. 2017, 23, 793–798. [Google Scholar] [CrossRef] [PubMed]
- Cheng, G.; Hao, H.; Xie, S.; Wang, X.; Dai, M.; Huang, L.; Yuan, Z. Antibiotic alternatives: The substitution of antibiotics in animal husbandry? Front. Microbiol. 2014, 5, 217. [Google Scholar] [CrossRef] [PubMed]
- Projan, S.J. Why is big Pharma getting out of antibacterial drug discovery? Curr. Opin. Microbiol. 2003, 6, 427–430. [Google Scholar] [CrossRef] [PubMed]
- Boggs, A.F.; Miller, G.H. Antibacterial drug discovery: Is small pharma the solution? Clin. Microbiol. Infect. 2004, 10, 32–36. [Google Scholar] [CrossRef] [PubMed]
- Hughes, D.; Karlén, A. Discovery and preclinical development of new antibiotics. Ups. J. Med. Sci. 2014, 119, 162–169. [Google Scholar] [CrossRef]
- Gajdács, M. The Concept of an Ideal Antibiotic: Implications for Drug Design. Molecules 2019, 24, 892. [Google Scholar] [CrossRef]
- Lewis, K. Platforms for antibiotic discovery. Nat. Rev. Drug Discov. 2013, 12, 371–387. [Google Scholar] [CrossRef]
- Gajdács, M.; Albericio, F. Antibiotic Resistance: From the Bench to Patients. Antibiotics 2019, 8, 129. [Google Scholar] [CrossRef]
- Wright, G.D. Antibiotic Adjuvants: Rescuing Antibiotics from Resistance. Trends Microbiol. 2016, 24, 862–871. [Google Scholar] [CrossRef] [PubMed]
- Kealey, C.; Creaven, C.A.; Murphy, C.D.; Brady, C.B. New approaches to antibiotic discovery. Biotechnol. Lett. 2017, 39, 805–817. [Google Scholar] [CrossRef] [PubMed]
- Alonso, C.D.; Mahoney, M.V. Bezlotoxumab for the prevention of Clostridium difficile infection: A review of current evidence and safety profile. Infect. Drug Resist. 2018, 12, 1–9. [Google Scholar] [CrossRef] [PubMed]
- Drawz, S.M.; Bonomo, R.A. Three Decades of β-Lactamase Inhibitors. Clin. Microbiol. Rev. 2010, 23, 160–201. [Google Scholar] [CrossRef]
- Tegos, G.P.; Haynes, M.; Strouse, J.J.; Khan, M.M.; Bologa, C.G.; Oprea, T.I.; Sklar, L.A. Microbial Efflux Pump Inhibition: Tactics and Strategies. Curr. Pharm. Des. 2011, 17, 1291–1302. [Google Scholar] [CrossRef]
- Spengler, G.; Kincses, A.; Gajdacs, M.; Amaral, L. New Roads Leading to Old Destinations: Efflux Pumps as Targets to Reverse Multidrug Resistance in Bacteria. Molecules 2017, 22, 468. [Google Scholar] [CrossRef]
- Calvert, M.B.; Jumde, V.R.; Titz, A. Pathoblockers or antivirulence drugs as a new option for the treatment of bacterial infections. Beilstein. J. Org. Chem. 2018, 14, 2607–2617. [Google Scholar] [CrossRef]
- Cegelski, L.; Marshall, G.R.; Eldridge, G.R.; Hultgren, S.J. The biology and future prospects of antivirulence therapies. Nat. Rev. Microbiol. 2008, 6, 17–27. [Google Scholar] [CrossRef]
- Brannon, J.R.; Hadjifrangiskou, M. The arsenal of pathogens and antivirulence therapeutic strategies for disarming them. Drug Des. Devel. 2016, 10, 1795–1806. [Google Scholar]
- Dickey, S.W.; Cheung, G.Y.C.; Otto, M. Different drugs for bad bugs: Antivirulence strategies in the age of antibiotic resistance. Nat. Rev. Drug Discov. 2017, 16, 457–471. [Google Scholar] [CrossRef]
- Lyons, B.J.E.; Strynadka, N.C.J. On the road to structure-based development of anti-virulence therapeutics targeting the type III secretion system injectisome. Med. Chem. Commun. 2019, 10, 1273–1289. [Google Scholar] [CrossRef] [PubMed]
- Totsika, M. Disarming pathogens: Benefits and challenges of antimicrobials that target bacterial virulence instead of growth and viability. Future Med. Chem. 2017, 9, 267–269. [Google Scholar] [CrossRef] [PubMed]
- Gutiérrez-Barranquero, J.A.; Reen, F.J.; McCarthy, R.R.; O’Gara, F. Deciphering the role of coumarin as a novel quorum sensing inhibitor suppressing virulence phenotypes in bacterial pathogens. Appl. Microbiol. Biotechnol. 2015, 99, 3303–3316. [Google Scholar] [CrossRef] [PubMed]
- Stewardson, A.; Gaia, N.; Francois, P.; Malhotra-Kumar, S.; Delemont, C.; Martinez de Tejada, B.; Schrenzel, J.; Harbarth, S.; Lazarevic, V.; Vervoort, J.; et al. Collateral damage from oral ciprofloxacin versus nitrofurantoin in outpatients with urinary tract infections: A culture-free analysis of gut microbiota. Clin. Microbiol. Infect. 2015, 21, 344.e1–344.e11. [Google Scholar] [CrossRef] [PubMed]
- Xue, H.; Li, J.; Xie, H.; Wang, Y. Review of Drug Repositioning Approaches and Resources. Int. J. Biol. Sci. 2018, 14, 1232–1244. [Google Scholar] [CrossRef] [PubMed]
- Miller, M.B.; Bassler, B.L. Quorum Sensing in Bacteria. Annu. Rev. Microbiol. 2001, 55, 165–199. [Google Scholar] [CrossRef]
- Jiang, Q.; Chen, J.; Yang, C.; Yin, Y.; Yao, K. Quorum Sensing: A Prospective Therapeutic Target for Bacterial Diseases. Available online: https://www.hindawi.com/journals/bmri/2019/2015978/ (accessed on 27 October 2019).
- Whiteley, M.; Diggle, S.P.; Greenberg, E.P. Bacterial quorum sensing: The progress and promise of an emerging research area. Nature 2017, 551, 313–320. [Google Scholar] [CrossRef]
- Abisado, R.G.; Benomar, S.; Klaus, J.R.; Dandekar, A.A.; Chandler, J.R. Bacterial Quorum Sensing and Microbial Community Interactions. mBio 2018, 9, e02331–e02417. [Google Scholar] [CrossRef]
- Kempner, E.S.; Hanson, F.E. Aspects of light production by Photobacterium fischeri. J. Bacteriol. 1968, 95, 975–979. [Google Scholar]
- Nealson, K.H.; Platt, T.; Hastings, J.W. Cellular control of the synthesis and activity of the bacterial luminescent system. J. Bacteriol. 1970, 104, 313–322. [Google Scholar]
- Eberhard, A. Inhibition and activation of bacterial luciferase synthesis. J. Bacteriol. 1972, 109, 1101–1105. [Google Scholar] [PubMed]
- Grandclément, C.; Tannières, M.; Moréra, S.; Dessaux, Y.; Faure, D. Quorum quenching: Role in nature and applied developments. FEMS Microbiol. Rev. 2016, 40, 86–116. [Google Scholar] [CrossRef] [PubMed]
- Gajdács, M.; Urbán, E. Epidemiological Trends and Resistance Associated with Stenotrophomonas maltophilia Bacteremia: A 10-Year Retrospective Cohort Study in a Tertiary-Care Hospital in Hungary. Diseases 2019, 7, 41. [Google Scholar] [CrossRef] [PubMed]
- Turovskiy, Y.; Kashtanov, D.; Paskhover, B.; Chikindas, M.L. Quorum Sensing: Fact, Fiction, and Everything in Between. Adv. Appl. Microbiol. 2007, 62, 191–234. [Google Scholar] [PubMed]
- Rutherford, S.T.; Bassler, B.L. Bacterial Quorum Sensing: Its Role in Virulence and Possibilities for Its Control. Cold Spring Harb. Perspect. Med. 2012, 2, a012427. [Google Scholar] [CrossRef] [PubMed]
- Fleitas Martínez, O.; Cardoso, M.H.; Ribeiro, S.M.; Franco, O.L. Recent Advances in Anti-virulence Therapeutic Strategies With a Focus on Dismantling Bacterial Membrane Microdomains, Toxin Neutralization, Quorum-Sensing Interference and Biofilm Inhibition. Front. Cell Infect. Microbiol. 2019, 9, 74. [Google Scholar] [CrossRef]
- Bhardwaj, A.K.; Vinothkumar, K.; Rajpara, N. Bacterial quorum sensing inhibitors: Attractive alternatives for control of infectious pathogens showing multiple drug resistance. Recent Pat. Anti-Infect. Drug Discov. 2013, 8, 68–83. [Google Scholar] [CrossRef]
- Pushpakom, S.; Iorio, F.; Eyers, P.A.; Escott, K.J.; Hopper, S.; Wells, A.; Doig, A.; Guilliams, T.; Latimer, J.; McNamee, C.; et al. Drug repurposing: Progress, challenges and recommendations. Nat. Rev. Drug Discov. 2019, 18, 41–58. [Google Scholar] [CrossRef]
- Paul, S.M.; Mytelka, D.S.; Dunwiddie, C.T.; Persinger, C.C.; Munos, B.H.; Lindborg, S.R.; Schacht, A.L. How to improve R&D productivity: The pharmaceutical industry’s grand challenge. Nat. Rev. Drug Discov. 2010, 9, 203–214. [Google Scholar]
- Miró-Canturri, A.; Ayerbe-Algaba, R.; Smani, Y. Drug Repurposing for the Treatment of Bacterial and Fungal Infections. Front. Microbiol. 2019, 10, 41. [Google Scholar] [CrossRef]
- Gatta, V.; Ilina, P.; Porter, A.; McElroy, S.; Tammela, P. Targeting Quorum Sensing: High-Throughput Screening to Identify Novel LsrK Inhibitors. Int. J. Mol. Sci. 2019, 20, 3112. [Google Scholar] [CrossRef] [PubMed]
- Yang, L.; Rybtke, M.T.; Jakobsen, T.H.; Hentzer, M.; Bjarnsholt, T.; Givskov, M.; Tolker-Nielsen, T. Computer-Aided Identification of Recognized Drugs as Pseudomonas aeruginosa Quorum-Sensing Inhibitors. AAC 2009, 53, 2432–2443. [Google Scholar] [CrossRef] [PubMed]
- Soo, V.W.C.; Kwan, B.W.; Quezada, H.; Castillo-Juárez, I.; Pérez-Eretza, B.; García-Contreras, S.J.; Martínez-Vázquez, M.; Wood, T.K.; García-Contreras, R. Repurposing of Anticancer Drugs for the Treatment of Bacterial Infections. Available online: http://www.eurekaselect.com/145957/article (accessed on 27 October 2019).
- Varga, B.; Csonka, Á.; Csonka, A.; Molnár, J.; Amaral, L.; Spengler, G. Possible Biological and Clinical Applications of Phenothiazines. Anticancer Res. 2017, 37, 5983–5993. [Google Scholar] [PubMed]
- Amaral, L.; Martins, A.; Spengler, G.; Molnar, J. Efflux pumps of Gram-negative bacteria: What they do, how they do it, with what and how to deal with them. Front. Pharm. 2014, 4, 168. [Google Scholar] [CrossRef] [PubMed]
- Galm, U.; Hager, M.H.; Van Lanen, S.G.; Ju, J.; Thorson, J.S.; Shen, B. Antitumor antibiotics: Bleomycin, enediynes, and mitomycin. Chem. Rev. 2005, 105, 739–758. [Google Scholar] [CrossRef] [PubMed]
- Young, C.W. Actinomycin and Antitumor Antibiotics. Am. J. Clin. Pathol. 1969, 52, 130–137. [Google Scholar] [CrossRef] [PubMed]
- Spengler, G.; Gajdács, M.; Marć, M.A.; Domínguez-Álvarez, E.; Sanmartín, C. Organoselenium Compounds as Novel Adjuvants of Chemotherapy Drugs-A Promising Approach to Fight Cancer Drug Resistance. Molecules 2019, 24, 336. [Google Scholar] [CrossRef] [PubMed]
- Ichikawa, Y.; Ghanefar, M.; Bayeva, M.; Wu, R.; Khechaduri, A.; Naga Prasad, S.V.; Mutharasan, R.K.; Naik, T.J.; Ardehali, H. Cardiotoxicity of doxorubicin is mediated through mitochondrial iron accumulation. J. Clin. Invest. 2014, 124, 617–630. [Google Scholar] [CrossRef] [PubMed]
- Ko, H.H.T.; Lareu, R.R.; Dix, B.R.; Hughes, J.D. Statins: Antimicrobial resistance breakers or makers? PeerJ 2017, 5, e3952. [Google Scholar] [CrossRef]
- Parihar, S.P.; Guler, R.; Khutlang, R.; Lang, D.M.; Hurdayal, R.; Mhlanga, M.M.; Suzuki, H.; Marais, A.D.; Brombacher, F. Statin Therapy Reduces the Mycobacterium tuberculosis Burden in Human Macrophages and in Mice by Enhancing Autophagy and Phagosome Maturation. J. Infect. Dis. 2014, 209, 754–763. [Google Scholar] [CrossRef] [PubMed]
- D’Angelo, F.; Baldelli, V.; Halliday, N.; Pantalone, P.; Polticelli, F.; Fiscarelli, E.; Williams, P.; Visca, P.; Leoni, L.; Rampioni, G. Identification of FDA-Approved Drugs as Antivirulence Agents Targeting the pqs Quorum-Sensing System of Pseudomonas aeruginosa. AAC 2018, 62, e01296–e01318. [Google Scholar] [CrossRef] [PubMed]
- Ashraf, S.; Chaudhry, U.; Raza, A.; Ghosh, D.; Zhao, X. In vitro activity of ivermectin against Staphylococcus aureus clinical isolates. Antimicrob. Resist. Infect. Control. 2018, 7, 27. [Google Scholar] [CrossRef]
- Thangamani, S.; Younis, W.; Seleem, M.N. Repurposing celecoxib as a topical antimicrobial agent. Front. Microbiol. 2015, 6, 750. [Google Scholar] [CrossRef] [PubMed]
- Kincses, A.; Varga, B.; Csonka, Á.; Sancha, S.; Mulhovo, S.; Madureira, A.M.; Ferreira, M.-J.U.; Spengler, G. Bioactive compounds from the African medicinal plant Cleistochlamys kirkii as resistance modifiers in bacteria. Phytother. Res. 2018, 32, 1039–1046. [Google Scholar] [CrossRef] [PubMed]
- Szabó, M.A.; Varga, G.Z.; Hohmann, J.; Schelz, Z.; Szegedi, E.; Amaral, L.; Molnár, J. Inhibition of quorum-sensing signals by essential oils. Phytother. Res. 2010, 24, 782–786. [Google Scholar] [CrossRef] [PubMed]
- Imperi, F.; Leoni, L.; Visca, P. Antivirulence activity of azithromycin in Pseudomonas aeruginosa. Front. Microbiol. 2014, 5, 178. [Google Scholar] [CrossRef]
- Christensen, L.D.; van Gennip, M.; Jakobsen, T.H.; Alhede, M.; Hougen, H.P.; Høiby, N.; Bjarnsholt, T.; Givskov, M. Synergistic antibacterial efficacy of early combination treatment with tobramycin and quorum-sensing inhibitors against Pseudomonas aeruginosa in an intraperitoneal foreign-body infection mouse model. J. Antimicrob. Chemother. 2012, 67, 1198–1206. [Google Scholar] [CrossRef]
- Henriksen, K.; Rørbo, N.; Rybtke, M.L.; Martinet, M.G.; Tolker-Nielsen, T.; Høiby, N.; Middelboe, M.; Ciofu, O.P. Aeruginosa flow-cell biofilms are enhanced by repeated phage treatments but can be eradicated by phage–ciprofloxacin combination—Monitoring the phage–P. aeruginosa biofilms interactions. Pathog. Dis. 2019, 77, ftz011. [Google Scholar] [CrossRef]
- Richter, A.M.; Fazli, M.; Schmid, N.; Shilling, R.; Suppiger, A.; Givskov, M.; Eberl, L.; Tolker-Nielsen, T. Key Players and Individualists of Cyclic-di-GMP Signaling in Burkholderia cenocepacia. Front. Microbiol. 2018, 9, 3286. [Google Scholar] [CrossRef]
- Bjarnsholt, T.; van Gennip, M.; Jakobsen, T.H.; Christensen, L.D.; Jensen, P.Ø.; Givskov, M. In vitro screens for quorum sensing inhibitors and in vivo confirmation of their effect. Nat. Protoc. 2010, 5, 282–293. [Google Scholar] [CrossRef]
- Gajdács, M. Resistance trends and epidemiology of Aeromonas and Plesiomonas infections (RETEPAPI): A 10-year retrospective survey. Infect. Dis. 2019, 51, 710–713. [Google Scholar] [CrossRef] [PubMed]
- Sciaky, D.; Montoya, A.L.; Chilton, M.-D. Fingerprints of Agrobacterium Ti plasmids. Plasmid 1978, 1, 238–253. [Google Scholar] [CrossRef]
- Lee, J.; Zhang, L. The hierarchy quorum sensing network in Pseudomonas aeruginosa. Protein Cell 2015, 6, 26–41. [Google Scholar] [CrossRef] [PubMed]
- Van Houdt, R.; Givskov, M.; Michiels, C.W. Quorum sensing in Serratia. FEMS Microbiol. Rev. 2007, 31, 407–424. [Google Scholar] [CrossRef] [PubMed]
- Surette, M.G.; Miller, M.B.; Bassler, B.L. Quorum sensing in Escherichia coli, Salmonella typhimurium, and Vibrio harveyi: A new family of genes responsible for autoinducer production. Proc. Natl. Acad. Sci. USA 1999, 96, 1639–1644. [Google Scholar] [CrossRef] [PubMed]
- Gajdács, M. The significance of bacterial quorum sensing (QS) inhibition in antivirulence therapy. In Diszciplínák Találkozása–Nyelvek és Kultúrák Érintkezése; Határhelyzetek; Hungarian Ministry of Foreign Affairs and Trade: Budapest, Hungary, 2019; Volume XI, pp. 396–406. ISBN 978-615-5389-72-6. [Google Scholar]
- Gajdács, M.; Burián, K.; Terhes, G. Resistance Levels and Epidemiology of Non-Fermenting Gram-Negative Bacteria in Urinary Tract Infections of Inpatients and Outpatients (RENFUTI): A 10-Year Epidemiological Snapshot. Antibiotics 2019, 8, 143. [Google Scholar] [CrossRef]
- Al-Bakri, A.G.; Othman, G.; Bustanji, Y. The assessment of the antibacterial and antifungal activities of aspirin, EDTA and aspirin-EDTA combination and their effectiveness as antibiofilm agents. J. Appl. Microbiol. 2009, 107, 280–286. [Google Scholar] [CrossRef]
- Givskov, M. Beyond nutrition: Health-promoting foods by quorum-sensing inhibition. Future Microbiol. 2012, 7, 1025–1028. [Google Scholar] [CrossRef]
- Ding, T.; Li, T.; Wang, Z.; Li, J. Curcumin liposomes interfere with quorum sensing system of Aeromonas sobria and in silico analysis. Sci. Rep. 2017, 7, 1–16. [Google Scholar] [CrossRef]
- Thangamani, S.; Mohammad, H.; Abushahba, M.F.N.; Sobreira, T.J.P.; Hedrick, V.E.; Paul, L.N.; Seleem, M.N. Antibacterial activity and mechanism of action of auranofin against multi-drug resistant bacterial pathogens. Sci. Rep. 2016, 6, 1–13. [Google Scholar] [CrossRef]
- Jakobsen, T.H.; Bragason, S.K.; Phipps, R.K.; Christensen, L.D.; van Gennip, M.; Alhede, M.; Skindersoe, M.; Larsen, T.O.; Høiby, N.; Bjarnsholt, T.; et al. Food as a source for quorum sensing inhibitors: Iberin from horseradish revealed as a quorum sensing inhibitor of Pseudomonas aeruginosa. Appl. Environ. Microbiol. 2012, 78, 2410–2421. [Google Scholar] [CrossRef]
- Antoniani, D.; Rossi, E.; Rinaldo, S.; Bocci, P.; Lolicato, M.; Paiardini, A.; Raffaelli, N.; Cutruzzolà, F.; Landini, P. The immunosuppressive drug azathioprine inhibits biosynthesis of the bacterial signal molecule cyclic-di-GMP by interfering with intracellular nucleotide pool availability. Appl. Microbiol. Biotechnol. 2013, 97, 7325–7336. [Google Scholar] [CrossRef] [PubMed]
- Paczkowski, J.E.; Mukherjee, S.; McCready, A.R.; Cong, J.-P.; Aquino, C.J.; Kim, H.; Henke, B.R.; Smith, C.D.; Bassler, B.L. Flavonoids Suppress Pseudomonas aeruginosa Virulence through Allosteric Inhibition of Quorum-sensing Receptors. J. Biol. Chem. 2017, 292, 4064–4076. [Google Scholar] [CrossRef] [PubMed]
- Kim, W.; Zou, G.; Hari, T.P.A.; Wilt, I.K.; Zhu, W.; Galle, N.; Faizi, H.A.; Hendricks, G.L.; Tori, K.; Pan, W.; et al. A selective membrane-targeting repurposed antibiotic with activity against persistent methicillin-resistant Staphylococcus aureus. Proc. Natl. Acad. Sci. USA 2019, 116, 16529–16534. [Google Scholar] [CrossRef] [PubMed]
- Gökalsın, B.; Aksoydan, B.; Erman, B.; Sesal, N.C. Reducing Virulence and Biofilm of Pseudomonas aeruginosa by Potential Quorum Sensing Inhibitor Carotenoid: Zeaxanthin. Microb. Ecol. 2017, 74, 466–473. [Google Scholar] [CrossRef]
- Bansal, T.; Englert, D.; Lee, J.; Hegde, M.; Wood, T.K.; Jayaraman, A. Differential Effects of Epinephrine, Norepinephrine, and Indole on Escherichia coli O157:H7 Chemotaxis, Colonization, and Gene Expression. Infect. Immun. 2007, 75, 4597–4607. [Google Scholar] [CrossRef]
- Sun, J.; Marais, J.P.J.; Khoo, C.; LaPlante, K.; Vejborg, R.M.; Givskov, M.; Tolker-Nielsen, T.; Seeram, N.P.; Rowley, D.C. Cranberry (Vaccinium macrocarpon) oligosaccharides decrease biofilm formation by uropathogenic Escherichia coli. J. Funct. Foods 2015, 17, 235–242. [Google Scholar] [CrossRef]
- Duan, J.; Li, M.; Hao, Z.; Shen, X.; Liu, L.; Jin, Y.; Wang, S.; Guo, Y.; Yang, L.; Wang, L.; et al. Subinhibitory concentrations of resveratrol reduce alpha-hemolysin production in Staphylococcus aureus isolates by downregulating saeRS. Emerg. Microbes Infect. 2018, 7, 1–10. [Google Scholar] [CrossRef]
- Zhang, Y.; Sass, A.; Van Acker, H.; Wille, J.; Verhasselt, B.; Van Nieuwerburgh, F.; Kaever, V.; Crabbé, A.; Coenye, T. Coumarin Reduces Virulence and Biofilm Formation in Pseudomonas aeruginosa by Affecting Quorum Sensing, Type III Secretion and C-di-GMP Levels. Front. Microbiol. 2018, 9, 1952. [Google Scholar] [CrossRef]
- Rajkumari, J.; Borkotoky, S.; Murali, A.; Suchiang, K.; Mohanty, S.K.; Busi, S. Attenuation of quorum sensing controlled virulence factors and biofilm formation in Pseudomonas aeruginosa by pentacyclic triterpenes, betulin and betulinic acid. Microb. Pathog. 2018, 118, 48–60. [Google Scholar] [CrossRef]
- Jakobsen, T.H.; van Gennip, M.; Phipps, R.K.; Shanmugham, M.S.; Christensen, L.D.; Alhede, M.; Skindersoe, M.E.; Rasmussen, T.B.; Friedrich, K.; Uthe, F.; et al. Ajoene, a sulfur-rich molecule from garlic, inhibits genes controlled by quorum sensing. Antimicrob. Agents Chemother. 2012, 56, 2314–2325. [Google Scholar] [CrossRef]
- Routh, M.M.; Chauhan, N.M.; Karuppayil, S.M. Cancer drugs inhibit morphogenesis in the human fungal pathogen, Candida albicans. Braz. J. Microbiol. 2013, 44, 855–859. [Google Scholar] [CrossRef] [PubMed][Green Version]
- Poli, J.-P.; Guinoiseau, E.; de Rocca Serra, D.; Sutour, S.; Paoli, M.; Tomi, F.; Quilichini, Y.; Berti, L.; Lorenzi, V. Anti-Quorum Sensing Activity of 12 Essential Oils on chromobacterium violaceum and Specific Action of cis-cis-p-Menthenolide from Corsican Mentha suaveolens ssp. Insularis. Molecules 2018, 23, 2125. [Google Scholar] [CrossRef] [PubMed]
- Hendrix, A.S.; Spoonmore, T.J.; Wilde, A.D.; Putnam, N.E.; Hammer, N.D.; Snyder, D.J.; Guelcher, S.A.; Skaar, E.P.; Cassat, J.E. Repurposing the Nonsteroidal Anti-inflammatory Drug Diflunisal as an Osteoprotective, Antivirulence Therapy for Staphylococcus aureus Osteomyelitis. Antimicrob. Agents Chemother. 2016, 60, 5322–5330. [Google Scholar] [CrossRef] [PubMed]
- Chavez-Dozal, A.A.; Lown, L.; Jahng, M.; Walraven, C.J.; Lee, S.A. In Vitro Analysis of Finasteride Activity against Candida albicans Urinary Biofilm Formation and Filamentation. AAC 2014, 58, 5855–5862. [Google Scholar] [CrossRef]
- Yeo, W.-S.; Arya, R.; Kim, K.K.; Jeong, H.; Cho, K.H.; Bae, T. The FDA-approved anti-cancer drugs, streptozotocin and floxuridine, reduce the virulence of Staphylococcus aureus. Sci. Rep. 2018, 8, 1–10. [Google Scholar] [CrossRef]
- Abbas, H.A.; Shaldam, M.A. Glyceryl trinitrate is a novel inhibitor of quorum sensing in Pseudomonas aeruginosa. Afr. Health Sci. 2016, 16, 1109–1117. [Google Scholar] [CrossRef]
- Ogundeji, A.O.; Pohl, C.H.; Sebolai, O.M. Repurposing of Aspirin and Ibuprofen as Candidate Anti-Cryptococcus Drugs. Antimicrob. Agents Chemother. 2016, 60, 4799–4808. [Google Scholar] [CrossRef]
- Gocmen, S.; Buyukkocak, U.; Caglayan, O. In vitro investigation of the antibacterial effect of ketamine. Ups. J. Med. Sci. 2008, 113, 39–46. [Google Scholar] [CrossRef]
- Johnson, S.M.; Saint John, B.E.; Dine, A.P. Local Anesthetics as Antimicrobial Agents: A Review. Surg. Infect. 2008, 9, 205–213. [Google Scholar] [CrossRef]
- Abbas, H.A.; Elsherbini, A.M.; Shaldam, M.A. Repurposing metformin as a quorum sensing inhibitor in Pseudomonas aeruginosa. Afr. Health Sci. 2017, 17, 808–819. [Google Scholar] [CrossRef]
- Koch, G.; Wermser, C.; Acosta, I.C.; Kricks, L.; Stengel, S.T.; Yepes, A.; Lopez, D. Attenuating Staphylococcus aureus Virulence by Targeting Flotillin Protein Scaffold Activity. Cell Chem. Biol. 2017, 24, 845–857.e6. [Google Scholar] [CrossRef] [PubMed]
- Imperi, F.; Massai, F.; Pillai, C.R.; Longo, F.; Zennaro, E.; Rampioni, G.; Visca, P.; Leoni, L. New Life for an Old Drug: The Anthelmintic Drug Niclosamide Inhibits Pseudomonas aeruginosa Quorum Sensing. Antimicrob. Agents Chemother. 2013, 57, 996–1005. [Google Scholar] [CrossRef] [PubMed]
- Kalia, M.; Yadav, V.K.; Singh, P.K.; Sharma, D.; Narvi, S.S.; Agarwal, V. Exploring the impact of parthenolide as anti-quorum sensing and anti-biofilm agent against Pseudomonas aeruginosa. Life Sci. 2018, 199, 96–103. [Google Scholar] [CrossRef] [PubMed]
- Gerits, E.; Defraine, V.; Vandamme, K.; Cremer, K.D.; Brucker, K.D.; Thevissen, K.; Cammue, B.P.A.; Beullens, S.; Fauvart, M.; Verstraeten, N.; et al. Repurposing Toremifene for Treatment of Oral Bacterial Infections. Antimicrob. Agents Chemother. 2017, 61, e01846–e01916. [Google Scholar] [CrossRef] [PubMed]
- Tintino, S.R.; Morais-Tintino, C.D.; Campina, F.F.; Pereira, R.L.; Costa, M.d.S.; Braga, M.F.B.M.; Limaverde, P.W.; Andrade, J.C.; Siqueira-Junior, J.P.; Coutinho, H.D.M.; et al. Action of cholecalciferol and alpha-tocopherol on Staphylococcus aureus efflux pumps. EXCLI J. 2016, 15, 315–322. [Google Scholar] [PubMed]
- Kwiecińska-Piróg, J.; Skowron, K.; Bogiel, T.; Białucha, A.; Przekwas, J.; Gospodarek-Komkowska, E. Vitamin C in the Presence of Sub-Inhibitory Concentration of Aminoglycosides and Fluoroquinolones Alters Proteus mirabilis Biofilm Inhibitory Rate. Antibiotics 2019, 8, 116. [Google Scholar] [CrossRef]
- Andrade, J.C.; Braga, M.F.B.M.; Guedes, G.M.M.; Tintino, S.R.; Freitas, M.A.; Quintans, L.J., Jr.; Menezes, I.R.A.; Coutinho, H.D.M. Cholecalciferol, Ergosterol, and Cholesterol Enhance the Antibiotic Activity of Drugs. Int. J. Vitam. Nutr. Res. 2018, 88, 244–250. [Google Scholar] [CrossRef]
- Andrade, J.C.; Morais Braga, M.F.B.; Guedes, G.M.M.; Tintino, S.R.; Freitas, M.A.; Quintans, L.J.; Menezes, I.R.A.; Coutinho, H.D.M. Menadione (vitamin K) enhances the antibiotic activity of drugs by cell membrane permeabilization mechanism. Saudi J. Biol. Sci. 2017, 24, 59–64. [Google Scholar] [CrossRef]
- Andrade, J.C.; Morais-Braga, M.F.B.; Guedes, G.M.M.; Tintino, S.R.; Freitas, M.A.; Menezes, I.R.A.; Coutinho, H.D.M. Enhancement of the antibiotic activity of aminoglycosides by alpha-tocopherol and other cholesterol derivates. Biomed. Pharmacother. 2014, 68, 1065–1069. [Google Scholar] [CrossRef]
- Hojo, M.; Asahara, T.; Nagahara, A.; Takeda, T.; Matsumoto, K.; Ueyama, H.; Matsumoto, K.; Asaoka, D.; Takahaski, T.; Nomoto, K.; et al. Gut Microbiota Composition Before and After Use of Proton Pump Inhibitors. Dig. Dis Sci. 2018, 63, 2940–2949. [Google Scholar] [CrossRef]
- Cha, C.; Gao, P.; Chen, Y.C.; Shaw, P.D.; Farrand, S.K. Production of acyl-homoserine lactone quorum-sensing signals by gram-negative plant-associated bacteria. Mol. Plant. Microbe Interact. 1998, 11, 1119–1129. [Google Scholar] [CrossRef] [PubMed]
- Morohoshi, T.; Shiono, T.; Takidouchi, K.; Kato, M.; Kato, N.; Kato, J.; Ikeda, T. Inhibition of Quorum Sensing in Serratia marcescens AS-1 by Synthetic Analogs of N-Acylhomoserine Lactone. Appl. Env. Microbiol. 2007, 73, 6339–6344. [Google Scholar] [CrossRef] [PubMed]
- Nacsa-Farkas, E.; Kerekes, E.B.; Hargitai, F.; Vágvölgyi, C.; Szegedi, E. Culture media supplemented with inorganic salts improve the growth and viability of several bacterial strains. Acta Biol. Szeged. 2016, 60, 151–156. [Google Scholar]

| Compounds | C. violaceum wt85 | C. violaceum CV026 | E. cloacae 31298 | S. paucimobilis Ezf 10-17 | Novosphingobium Spp. Rr 2-17 | S. marcescens AS-1 | E. coli ATCC 25922 | S. aureus ATCC 25923 |
|---|---|---|---|---|---|---|---|---|
| celecoxib | >250 | >250 | >250 | >250 | >250 | >250 | >250 | 15.6 |
| mebendazole | 62.5 | 62.5 | 125 | 62.5 | 62.5 | 31.3 | 125 | 62.5 |
| ivermectin | >250 | >250 | >250 | >250 | >250 | >250 | >250 | 31.3 |
| verapamil | >250 | >250 | >250 | 250 | 250 | >250 | >250 | 250 |
| promethazine | 31.3 | 31.3 | >250 | >250 | 250 | 125 | >250 | >250 |
| chlorpromazine | 15.6 | 15.6 | 125 | 62.5 | 62.5 | 62.5 | >250 | >250 |
| thioridazine | 15.6 | 15.6 | 62.5 | 31.3 | 31.3 | 15.6 | 31.3 | 125 |
| methotrexate | 125 | 125 | >250 | 125 | 125 | >250 | >250 | >250 |
| doxorubicin | 125 | 125 | 250 | 250 | 250 | 125 | 125 | 62.5 |
| bleomycin | 125 | 125 | 125 | 250 | 250 | >250 | 125 | 62.5 |
| atorvastatin | 125 | 125 | 31.3 | >250 | >250 | 125 | >250 | 62.5 |
| simvastatin | 250 | 250 | 62.5 | >250 | >250 | 125 | >250 | 125 |
| clotrimazole | >250 | >250 | >250 | >250 | >250 | >250 | >250 | 125 |
| fluconazole | >250 | >250 | >250 | >250 | >250 | >250 | >250 | 62.5 |
| DMSO | >2 V/V% | >2 V/V% | > 2 V/V% | >2 V/V% | >2 V/V% | >2 V/V% | >2 V/V% | >2 V/V% |
| Pharmacological Agents | Food-Derived Compounds |
|---|---|
| acetyl-salicylic acid [84] | pepper [85] |
| antifungal azoles [67] | curcumin [86] |
| auranofin [87] | horse raddish [88] |
| azathioprine [89] | flavonoids [90] |
| bithionol [91] | zeaxantin [92] |
| catecholamines [93] | cranberry juice [94] |
| celecoxib [69] | resveratrol [95] |
| coumarines [37,96] | betulinic acid [97] |
| chloroxazone [57] | ajoene [98] |
| daunorubicin [99] | essential oils [71,94,100] |
| diflunisal [101] | |
| finasteride [102] | |
| floxuridine [103] | |
| glyceryl-trinitrate [104] | |
| ibuprofen [105] | |
| ivermectin [68] | |
| local anesthetics [106,107] | |
| general anesthetics [106,107] | |
| metformin [108] | |
| miltefosine [109] | |
| niclosamide [110] | |
| parthenolide [111] | |
| toremifene [112] | |
| statins [65,66] | |
| streptozotocin [103] | |
| Vitamin A [113] | |
| Vitamin C [114] | |
| Vitamin D [113,115,116] | |
| Vitamin K [117] |
© 2019 by the authors. Licensee MDPI, Basel, Switzerland. This article is an open access article distributed under the terms and conditions of the Creative Commons Attribution (CC BY) license (http://creativecommons.org/licenses/by/4.0/).
Share and Cite
Gajdács, M.; Spengler, G. The Role of Drug Repurposing in the Development of Novel Antimicrobial Drugs: Non-Antibiotic Pharmacological Agents as Quorum Sensing-Inhibitors. Antibiotics 2019, 8, 270. https://doi.org/10.3390/antibiotics8040270
Gajdács M, Spengler G. The Role of Drug Repurposing in the Development of Novel Antimicrobial Drugs: Non-Antibiotic Pharmacological Agents as Quorum Sensing-Inhibitors. Antibiotics. 2019; 8(4):270. https://doi.org/10.3390/antibiotics8040270
Chicago/Turabian StyleGajdács, Márió, and Gabriella Spengler. 2019. "The Role of Drug Repurposing in the Development of Novel Antimicrobial Drugs: Non-Antibiotic Pharmacological Agents as Quorum Sensing-Inhibitors" Antibiotics 8, no. 4: 270. https://doi.org/10.3390/antibiotics8040270
APA StyleGajdács, M., & Spengler, G. (2019). The Role of Drug Repurposing in the Development of Novel Antimicrobial Drugs: Non-Antibiotic Pharmacological Agents as Quorum Sensing-Inhibitors. Antibiotics, 8(4), 270. https://doi.org/10.3390/antibiotics8040270
